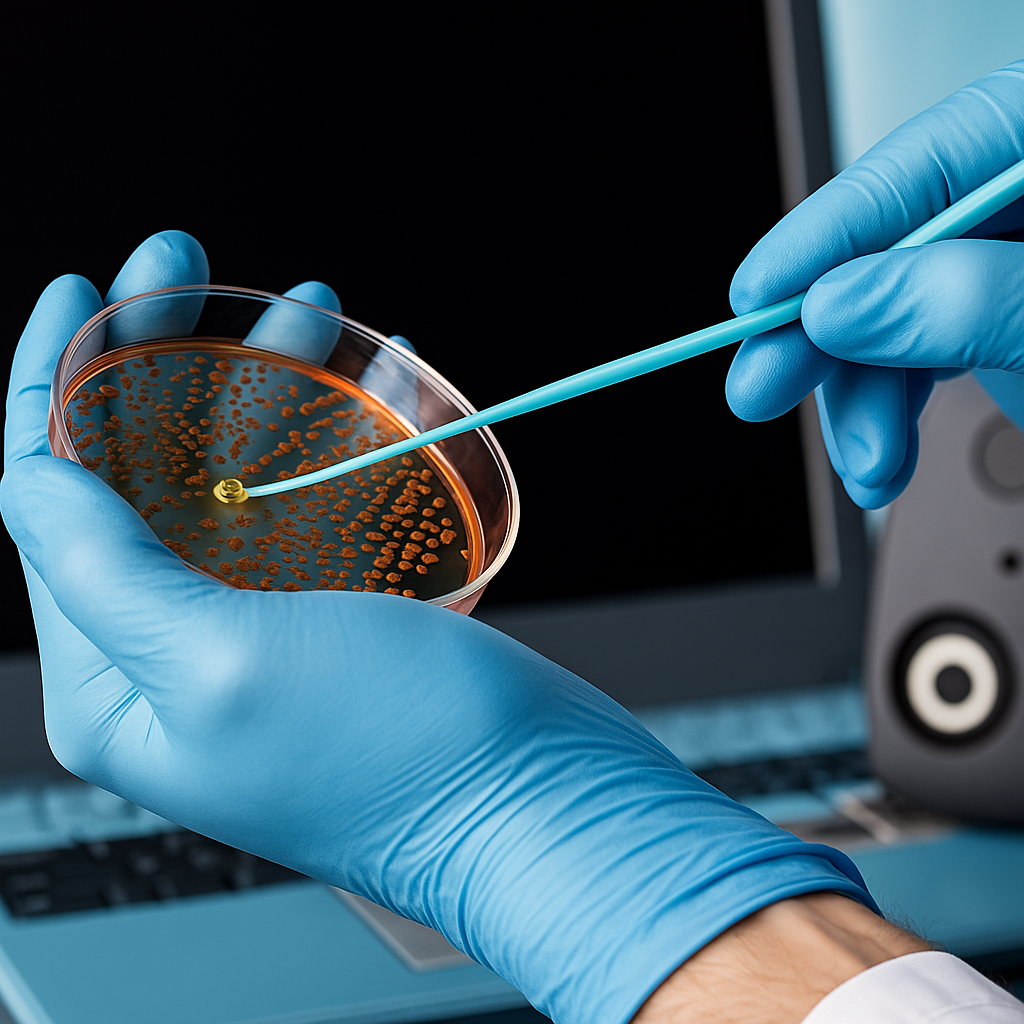
Campionamenti

INOSTRI SERVIZI
-
![]()
VALIDAZIONI
Servizi di validazione e qualificazione in ambito GMP, GLP, GCP e ISO per laboratori e industrie Life Sciences
Offriamo supporto completo nella validazione e nella redazione di protocolli GMP, GLP, GCP e ISO , includendo:
Qualifica IQ, OQ, PQ di apparecchiature
Validazione di processi critici (CIP/SIP, sterilizzazioni, decontaminazioni, fermentazione, lavaggio, stoccaggio, processi di produzione primaria e secondaria)
Validazione camere bianche e HVAC
Qualifica di cappe a flusso laminare, incubatori, essiccatori
Validazione catena del freddo frigoriferi e celle.
-
![Gruppo di professionisti in una riunione, alcuni in abiti medici, attorno a un tavolo con un laptop. Sfondo di una sala conferenze con schermo.]()
AUDIT PRE ISPETTIVI GMP-FDA
Prepariamo la tua azienda a superare audit e ispezioni GMP.
Offriamo servizi integrati di audit pre-ispettivi, consulenza e formazione per assicurare conformità, efficienza e risultati concreti.formazione mirata del personale su GMP, procedure operative, e consulenza specialistica in materia di sicurezza sul lavoro e tutela ambientale in conformità al DL 81/08 e DL 152/06.
Supportiamo le aziende nella redazione di SOP chiare, conformi e orientate all’efficienza operativa.
Audit Pre-Ispettivi: Preparazione e conduzione di audit pre-ispettivi per enti regolatori come AIFA, EMA e FDA.
-
MONITORAGGIO AMBIENTALE
Monitoraggio Ambientale: Servizi di monitoraggio ambientale in aree classificate e non classificate.
Monitoraggio particellare e controllo delle utilities critiche come aria compressa (CA), vapore, acqua per iniezione (WFI) e acqua purificata (PW)
-
![]()
CALIBRAZIONI
Calibrazione Certificata di Strumenti di Misura
Eseguiamo la calibrazione e certificazione di strumenti e sonde di temperatura, umidità, pressione, pH, conducibilità, portata, peso e velocità.
Servizi inclusi: bilance, termometri, sonde, manometri, flussimetri, pHmetri, RPM, oltre a misure su flussi d’aria e impatto acustico
-
![]()
AINOVATECH
Supporto per l'Implementazione di Intelligenza Artificiale (AiNovaTech): Sviluppo e integrazione di soluzioni di intelligenza artificiale avanzate per ottimizzare i processi produttivi, garantire la conformità normativa, migliorare l'efficienza operativa, ridurre i rischi e supportare la digitalizzazione industriale attraverso machine learning e algoritmi basati su standard GMP e ISO.
-
![Investigatore forense CTP CTU]()
Indagini Tecniche Specialistiche & Supporto Tecnico
ABNovaTech fornisce supporto tecnico-scientifico per attività di accertamento e analisi specialistica nei seguenti ambiti:
Industria Farmaceutica
Verifiche su processi produttivi, conformità GMP, analisi tecnica di eventi critici, contaminazioni e anomalie di processo.
Industria Chimica e Ambientale
Accertamenti tecnico-strumentali su emissioni, sostanze, matrici ambientali e ricostruzione tecnica di eventi industriali.
Settore Alimentare e Cosmetico
Analisi tecnica di non conformità, contaminanti, qualità di prodotto e verifica documentale.
Ambito Assicurativo e Legale
Supporto tecnico a studi legali e consulenti per analisi oggettive, accertamenti specialistici e relazioni tecniche di parte.
ABNovaTech opera con metodologia documentata e tracciabile, collaborando con laboratori accreditati per garantire affidabilità, riproducibilità e validità tecnica dei risultati.
-
CAMPIONAMENTI BIOLOGICI E MICROBIOLOGICI
Campionamenti Biologici e Microbiolocici
ABNovaTech offre servizi di campionamento biologico e microbiologico per il controllo della contaminazione, dalle Life Sciences alla chimica forense. I servizi comprendono il prelievo controllato di aria, superfici, acque e ambienti critici, con metodologie validate e tracciabilità completa dei dati a supporto di analisi, verifiche di conformità e indagini tecniche per enti pubblici e privati.